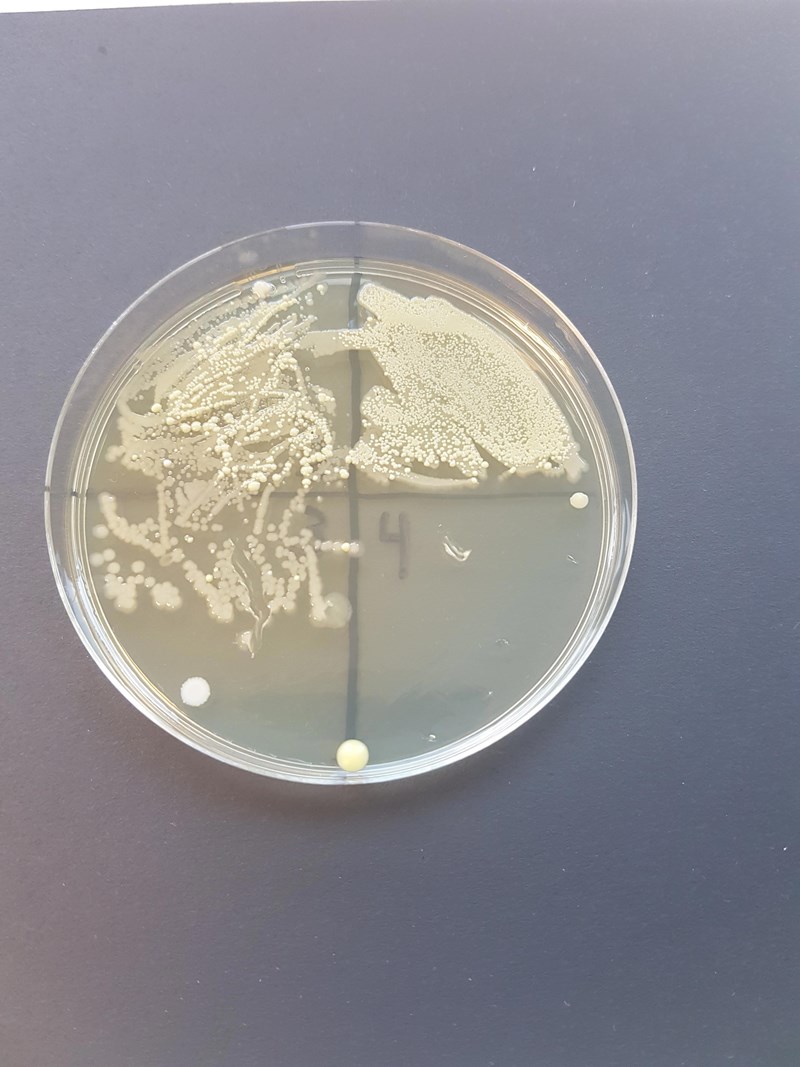

0
svar
234
visningar
Utstryksmetoden
När vi använda utstryksmetoden så tog vi en droppe vätska ifrån en okänd blandning av två sorters bakterier. Vad är det som gör att de vita kolonierna har växt på en plats och då gula kolonierna har växt på en annan. Borde det inte vara så att de skulle ha växt blandat eftersom det är inte så att det fanns bara en sorts bakterie vid utstrykningen liksom de fanns ju i samma behållare. Har nån en bra och tydlig förklaring tack. Snabba svar uppskattas gärna (labbrapport ska in 23.55 idag)
När vi använda utstryksmetoden så tog vi en droppe vätska ifrån en okänd blandning av två sorters bakterier. Vad är det som gör att de vita kolonierna har växt på en plats och då gula kolonierna har växt på en annan. Borde det inte vara så att de skulle ha växt blandat eftersom det är inte så att det fanns bara en sorts bakterie vid utstrykningen liksom de fanns ju i samma behållare. Har nån en bra och tydlig förklaring tack. Snabba svar uppskattas gärna (labbrapport ska in 23.55 idag)

